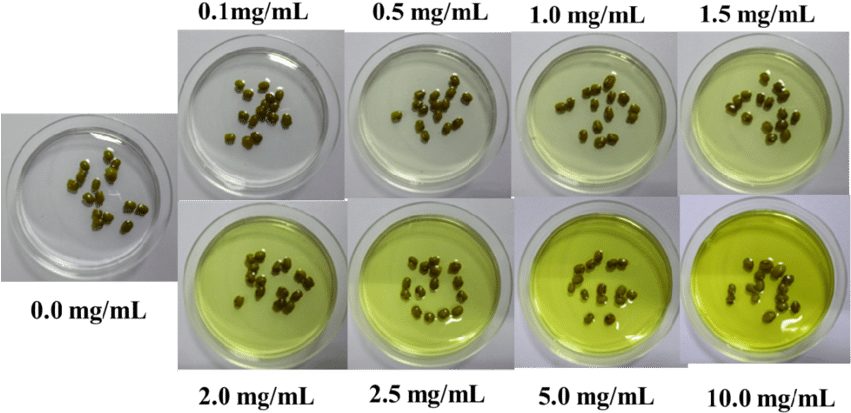
S10 Growth Of Green Beans After 0 H At Different Concentration - Concentration (850x441), Png Download

S10 Growth Of Green Beans After 0 H At Different Concentration - Concentration
Share
: S10 Growth Of Green Beans After 0 H At Different Concentration - Concentration
Format: PNG
Dimensions: 850x441 px
Size: 152 KB
Downloads: 2
Report image
Are you looking for S10 Growth Of Green Beans After 0 H At Different Concentration - Concentration? The PNG image provided by SeekPNG is high quality and free unlimited download. Its resolution is 850x441 and with no background, which can be used in a variety of creative scenes. The PNG image of S10 Growth Of Green Beans After 0 H At Different Concentration - Concentration is classified as green bay packers png,h logo png,growth png. You can search and download the PNG image material you need without limit on SeekPNG.
Short Link (Direct Image Link)
Code for Inserting an Image for Your Blog or Website